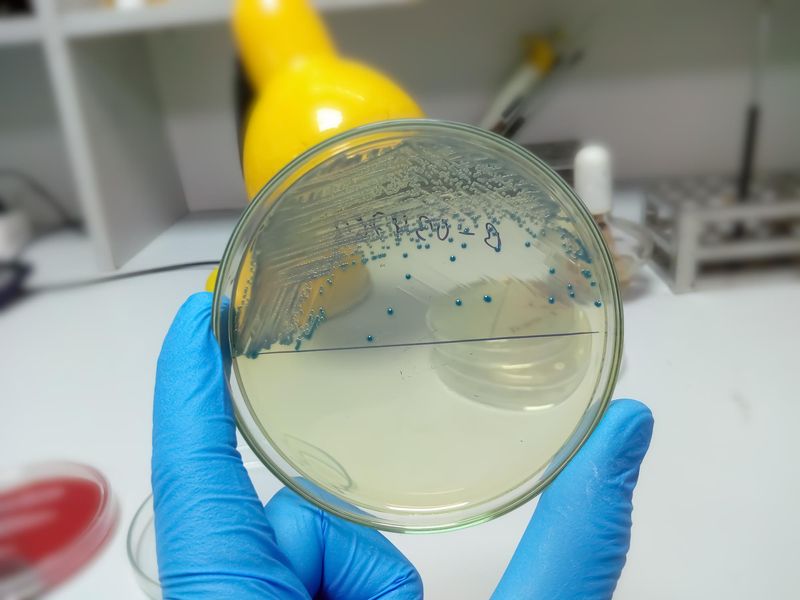

06
Список
литературы
Прокофьева А.К. Значение личной и общественной профилактики микозов в местах общественного пользования [Электронный ресурс] // Актуальные проблемы гуманитарных и естественных наук. 2014
Смирнова О.В., Литвак Николай И. Микозы кожи: «Перспективная» инфекция [Электронный ресурс] // Ремедиум. Журнал о российском рынке лекарств и медицинской технике. 2015
Борисов Л.Б., Смирнова А.М. Медицинская микробиология, вирусология, иммунология. Учебная литература для студентов медицинских институтов // Медицина. 2004
Скрипкина Ю.К. Кожные и венерические болезни // Медицина. 2006
Antinori S., Ridolfo A., Casalini G., Giacomelli A. Endemic mycoses: geographical distribution is still a work in progress [Электронный ресурс] // The Lancet Infectious Diseases. 2022 https://www.researchgate.net/publication/359445286_Endemic_mycoses_geographical_distribution_is_still_a_work_in_progress